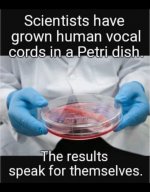
1729533732747.jpeg

and help to keep the site free for all
You are using an out of date browser. It may not display this or other websites correctly.
You should upgrade or use an alternative browser.
You should upgrade or use an alternative browser.
The Official TP Funnies thread ( Jokes Memes etc )
- Thread starter Cobra
- Start date
ancient_mariner
Moderator
- Messages
- 28,070
- Name
- Toni
- Edit My Images
- No
ancient_mariner
Moderator
- Messages
- 28,070
- Name
- Toni
- Edit My Images
- No
ancient_mariner
Moderator
- Messages
- 28,070
- Name
- Toni
- Edit My Images
- No
- Messages
- 34,440
- Name
- George.
- Edit My Images
- No
A wife saw her husband weigh himself on the scale trying to pull in the stomach. The wife thought he was trying to reduce his weight on the scale. So she said, "You know, I don't think that will help you." The husband replies, "Of course it helps. It is the only way I can see the number on the scale."
- Messages
- 34,440
- Name
- George.
- Edit My Images
- No
A teacher asks little Johnny if he knows his one to 10 well. "Yes! Of course! My pop taught me, even more than 10!" "Good. What comes after three?” "Four." "What comes after six?" "Seven." "Very good," says the teacher. "Your dad did a good job. Now, what comes after, let's say 10?" "A jack."
badlywornroy
I am not macho
- Messages
- 2,714
- Name
- Roy
- Edit My Images
- No
When I 'fall of my perch' my wife is going to take me to one of those fish spas where the little fish nibble away all the dead skin. It costs £35.00 but it is still a lot cheaper than a funeral.
D
Deleted member 68495
Guest
This is true.
A guy in the street was doing a video for YouTube and he spoke to a pair of girls. To the first one, he said, "Give me a number between 1 and 1 million." She replied, "Five."
The man said, "Ok, here's five dollars," and promptly handed five dollars to the girl.
He then said to the second girl, "Give me a number between 1 and 1 million."
And I kid you not, she said, "Six."
A guy in the street was doing a video for YouTube and he spoke to a pair of girls. To the first one, he said, "Give me a number between 1 and 1 million." She replied, "Five."
The man said, "Ok, here's five dollars," and promptly handed five dollars to the girl.
He then said to the second girl, "Give me a number between 1 and 1 million."
And I kid you not, she said, "Six."
ancient_mariner
Moderator
- Messages
- 28,070
- Name
- Toni
- Edit My Images
- No
For those struggling with imperial and metric conversions, here are some handy references.
2000 mockingbirds = two kilomockingbirds
52 = 1 decacards
½ lavatory = 1 demijohn
1 millionth of a fish = 1 microfiche
10 rations = 1 decoration
10 millipede = 1 centipede
3 1/3 tridents = 1 decadent
10 monologues = 5 dialogues
2 monograms = 1 diagram
8 nickels = 2 paradigms
2000 mockingbirds = two kilomockingbirds
52 = 1 decacards
½ lavatory = 1 demijohn
1 millionth of a fish = 1 microfiche
10 rations = 1 decoration
10 millipede = 1 centipede
3 1/3 tridents = 1 decadent
10 monologues = 5 dialogues
2 monograms = 1 diagram
8 nickels = 2 paradigms
ancient_mariner
Moderator
- Messages
- 28,070
- Name
- Toni
- Edit My Images
- No
TheBigYin
Moderator
- Messages
- 17,028
- Name
- Mark
- Edit My Images
- No
I know Fries, I Have the Best Fries...